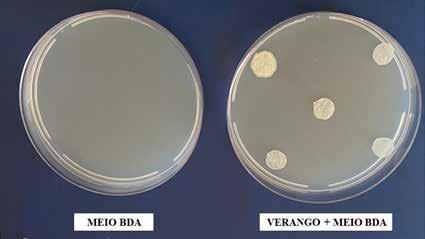

7 minute read
Informe Bayer - Compatibilidade testada
Compatibilidade testada
Produtos biológicos à base de Bacillus methylotrophicus, Bacillus subtilis, Trichoderma asperellum, Pochonia chlamydosporia, Metharizium anisopliae, Paecillomices lillacinus, Trichoderma harzianun, Bacillus subtilis + B. licheniformis e Beauveria bassiana se mostram compatíveis com o nematicida químico Fluopiram
Mais de cem espécies de nematoides envolvendo aproximadamente 50 gêneros estão associadas à cultura da soja. No Brasil, as espécies que causam maiores danos são Meloidogyne javanica, Meloidogyne incognita, Heterodera glycines, Pratylenchus brachyurus e Rotylenchulus reniformis. A importância dessas espécies para o País se deve a aspectos relevantes, como a presença endêmica em diversas regiões produtoras (M. javanica e M. incognita), elevada variabilidade genética (H. glycines) e risco potencial de dano com o incremento da área cultivada com espécies suscetíveis (P. brachyurus e R. reniformis).
Os sintomas relacionados ao ataque desses fitoparasitas se assemelham muito. Em áreas com a presença de nematoide é comum encontrar reboleiras com plantas atrofiadas e cloróticas. Em casos extremos, com densidades populacionais elevadas, pode ocorrer a morte de plantas. No entanto, esses indicativos não podem ser únicos para diagnosticar uma área com fitonematoides. A presença de reboleiras pode estar associada a manchas de calcário e a clorose com uma deficiência nutricional, déficit hídrico e compactação do solo. Dessa forma, realizar análises específicas para a identificação correta da espécie do nematoide presente na área é de extrema importância para o sucesso no seu manejo.
Diversas estratégias podem ser empregadas no manejo de nematoides na cultura da soja, com destaque para aquelas baseadas na utilização de produtos químicos e biológicos. Esses produtos geralmente podem ser aplicados via tratamento de semente ou sulco de plantio e visam à redução populacional do patógeno e dos danos por ele ocasionados.
A associação de nematicidas químicos e biológicos em uma mesma aplicação tem sido bastante empregada nos dias atuais. No entanto, para que essa junção de ferramentas não prejudique a performance dos produtos, é de fundamental importância compreender a compatibilidade desses produtos. Com o objetivo de avaliar a compatibilidade de produtos biológicos registrados para o manejo de nematoides com o nematicida químico Verango Prime®, foram conduzidos dois ensaios em condições controladas no Laboratório de Manejo Integrado de Nematoides (Labmin) do IF Goiano – Campus Urutaí (GO) e na Agromax, em Primavera do Leste (MT).
Foi avaliada a compatibilidade do produto químico Verango Prime com outros produtos biológicos disponíveis no mercado passíveis de serem aplicados em conjunto, em condições de laboratório.
Tabela 1 - Resultados do teste de compatibilidade produtos biológicos com o nematicida químico Verango Prime, em condições controladas. Urutaí, Goiás e Primavera do Leste, Mato Grosso, 2020
Agente de biocontrole Testemunha Bacillus methylotrophicus Bacillus subtilis Bacillus subtilis Trichoderma asperellum Pochonia chlamydosporia Metharizium anisopliae Paecillomices lillacinus Trichoderma harzianun Bacillus subtilis + B. licheniformis Beauveria bassiana
Nome comercial --Onix Serenade Rizos Quality Rizotec Metarril Nemat Ecotrich Presence Boveril Compatibilidade1 com Verango Prime --C C C C C C C C C C

Figura 1 - Ausência de halo de inibição ao redor do disco de papel de filtro no teste de compatibilidade do Produto Onix (Bacillus methylotrophicus) com Verango Prime (Fluopiram), demonstrando a compatibilidade entre os produtos
Figura 2 - Ausência de halo de inibição ao redor do disco de papel de filtro no teste de compatibilidade do Produto Serenade (Bacillus subtilis) com Verango Prime (Fluopiram), demonstrando a compatibilidade entre os produtos Figura 4 - Ausência de halo de inibição ao redor do disco de papel de filtro no teste de compatibilidade do Produto Quality (Trichoderma asperellum) com Verango Prime (Fluopiram), demonstrando a compatibilidade entre os produtos


Os produtos avaliados nos ensaios foram: Bacillus methylotrophicus (Onix – Lab. Farroupilha / Lallemand); Bacillus subtilis (Serenade - Bayer); Bacillus subtilis (Rizos – Lab. Farroupilha / Lallemand); Trichoderma asperellum (Quality – Lab. Farroupilha / Lallemand); Pochonia chlamydosporia (Rizotec – Stoller); Metharizium anisopliae (Metarril – Koppert); Paecillomices lillacinus (Nemat – Ballagro); Trichoderma harzianun (Ecotrich – Ballagro); Bacillus subtilis + B. licheniformis (Presence | Quartzo – FMC) e Beauveria bassiana (Boveril – Koppert).
Para os testes foram utilizadas as doses recomendadas pelos fabricantes dos respectivos produtos comerciais. Para a avaliação de compatibilidade dos produtos à base de fungos foi utilizado o meio de cultura Batata–Dextrose–Ágar (BDA) sem adição de antibiótico. Para os testes com os produtos à base de bactéria o meio utilizado também foi o BDA, com adição de 1.000 miligramas de antibiótico por litro de meio de cultura. Os produtos avaliados foram diluídos e colocados em placas de Petri, de 8cm de diâmetro, em formas de estrias com o auxílio da alça de Drigalsky. Foram utilizadas três placas de Petri para cada tratamento, sendo que duas placas receberam discos de papel de filtro embebido com Verango Prime e uma placa permaneceu como testemunha contendo apenas o produto biológico.
Discos de papel de filtro de 1cm de diâmetro foram mergulhados na calda de Verango Prime e colocados em contato com a superfície do meio de cultura já inoculado com o respectivo agente de biocontrole, sendo cinco discos por placa. As placas foram colocadas em câmara de crescimento D.B.O a temperatura de 26°C, com 12 horas de luz e 12 horas com ausência de luz.
Figura 3 - Ausência de halo de inibição ao redor do disco de papel de filtro no teste de compatibilidade do Produto Rizos (Bacillus subtilis) com Verango Prime (Fluopiram), demonstrando a compatibilidade entre os produtos Figura 5 - Ausência de halo de inibição ao redor do disco de papel de filtro no teste de compatibilidade do Produto Rizotec (Pochonia chlamydosporia) com Verango Prime (Fluopiram), demonstrando a compatibilidade entre os produtos


Figura 6 - Ausência de halo de inibição ao redor do disco de papel de filtro no teste de compatibilidade do Produto Metarril (Metharizium anisopliae) com Verango Prime (Fluopiram), demonstrando a compatibilidade entre os produtos

Avaliou-se a presença do halo de inibição no crescimento das colônias ao redor dos discos. O produto que apresentou halo de inibição ao redor do disco de papel foi classificado como incompatível e o produto que não apresentou halo foi classificado como compatível (Silva et al., 2008). Para os produtos à base de bactéria, as avaliações de compatibilidade foram realizadas após 48 horas de incubação e para os produtos à base de fungo, sete dias após a incubação.
O resultado de compatibilidade de cada produto biológico com o nematicida químico Verango Prime está expresso na Tabela 1. Ressalta-se que todos os produtos foram classificados como compatíveis, uma vez que não foi observado halo de inibição ao redor do disco de papel de filtro (Figuras 1 a 11).
Dessa forma, é possível concluir que os produtos à base de Bacillus methylotrophicus (Onix), Bacillus subtilis (Serenade), Bacillus subtilis (Rizos), Trichoderma asperellum (Quality), Pochonia chlamydosporia (Rizotec), Metharizium anisopliae (Metarril), Paecillomices lillacinus (Nemat), Trichoderma harzianun (Ecotrich), Bacillus subtilis + B. licheniformis (Presence), Beauveria bassiana (Boveril) são compatíveis com o nematicida químico Fluopiram (Verango Prime).
C C
Fernando Godinho de Araújo, Instituto Federal de Educação, Ciência e Tecnologia Goiano - Polo de Inovação Tatiane Zambiasi, Agromax Pesquisa e Desenvolvimento Agrícola Adriana Figueiredo, Bayer Crop Science
Figura 8 - Ausência de halo de inibição ao redor do disco de papel de filtro no teste de compatibilidade do Produto Ecotrich (Trichoderma harzianun) com Verango Prime (Fluopiram), demonstrando a compatibilidade entre os produtos

Figura 9 - Ausência de halo de inibição ao redor do disco de papel de filtro no teste de compatibilidade do Produto Presence (Bacillus subtilis + B. licheniformis) com Verango Prime (Fluopiram), demonstrando a compatibilidade entre os produtos

Figura 10 - Ausência de halo de inibição ao redor do disco de papel de filtro no teste de compatibilidade do Produto Boveril (Beauveria bassiana) com Verango Prime (Fluopiram), demonstrando a compatibilidade entre os produtos

Figura 7 - Ausência de halo de inibição ao redor do disco de papel de filtro no teste de compatibilidade do Produto Nemat (Paecillomices lillacinus) com Verango Prime (Fluopiram), demonstrando a compatibilidade entre os produtos Figura 11 - Meio de cultura batata-dextrose-ágar (BDA) e com Verango Prime (Fluopiram), demonstrando ausência de contaminação